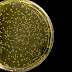

Το ιστολόγιο "Τέχνης Σύμπαν και Φιλολογία" είναι ένας διαδικτυακός τόπος που αφιερώνεται στην προώθηση και ανάδειξη της τέχνης, της επιστήμης και της φιλολογίας. Ο συντάκτης του ιστολογίου, Κωνσταντίνος Βακουφτσής, μοιράζεται με τους αναγνώστες του τις σκέψεις του, τις αναλύσεις του και την αγάπη του για τον πολιτισμό, το σύμπαν και τη λογοτεχνία.
Πέμπτη 30 Μαΐου 2019
Παρασκευή 24 Μαΐου 2019